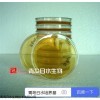
32724P-1 胰酪大豆胨琼脂培养基TSA日水生物

青岛日水生物技术有限公司
微生物培养基|培养基的配方|培养基研发销售平台|干粉培养基|一次性接触皿平板青岛日水生物是微生物检测培养基研发、生产和销售的国家高薪技术企业。成立于2010年,是目前国内产品种类齐全的微生物培养基生产厂家。作为国内国产专业微生物培养基口碑好,品质好,服务好,信誉好,质量好的实惠销售平台,公司致力于打造中国较好的培养基品牌和生产企业。公司包括研发部、质量控制与检验部、生产部、仓储部、销售部和办公生活区,实现从研发到生产销售一体的培养基现货供应服务商!
公司产品广泛应用于国家检验检疫机构、食品、制药、环境监测、水质检测、科研等领域;为微生物检验提供全面的解决方案,可灵活定制干粉培养基,以较大化满足客户的不同需求。
2018年公司致力于打造中国专业的培养基生产供应商!争做国内口碑好的微生物培养基专业品牌商!引领行内 制造企业和服务商!
产品系列:2015版药典干粉培养基、固体培养基、液体培养基、显色培养基、一次性无菌表面培养皿平板、表面接触碟、生化鉴定管,质控菌株等。
青岛日水生物详见网站

浙公网安备 33010502000340号
浙公网安备 33010502000340号





